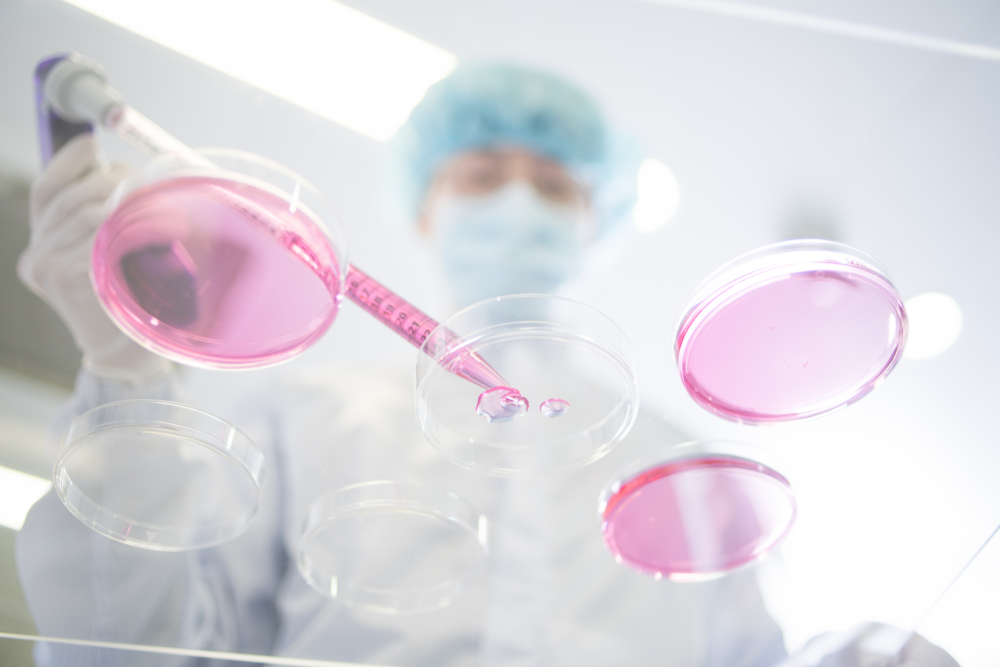
(사진제공=메디포스트)

메디포스트는 알츠하이머병 치료제 ‘뉴로스템’의 국내 1·2a상 임상시험이 종료됐다고 6일 밝혔다.
뉴로스템은 제대혈(탯줄 내 혈액) 유래 간엽줄기세포를 이용한 알츠하이머성 치매 치료제다. 아밀로이드 베타 감소, 타우 단백질의 과인산화 차단 등의 작용을 통해 신경세포 사멸을 억제해 질병을 치료하는 것을 목표로 하고 있다.
임상시험은 2014년부터 삼성서울병원에서 실시됐다. 1단계 10명, 2단계 36명 등 총 46명의 환자를 대상으로 안전성 및 탐색적 유효성을 평가했다. 뇌에 삽입된 특수관(Ommaya Reservoir)을 통해 뇌실에 직접 투여하는 방식으로 이뤄졌으며 각각 한 달 간격으로 3회 반복 투여했다.
대표적인 노인성 질환인 알츠하이머병은 기억력, 언어, 지각, 감정 조절 능력이 심각하게 저하돼 정상적인 삶을 유지할 수 없는 심각한 질환이지만 현재까지 전 세계적으로 근본적인 치료제는 없다. 중앙치매센터에 따르면 국내 치매 환자 수는 2018년 기준 75만 명이며 이중 약 72.5%가 알츠하이머성 치매를 앓고 있는 것으로 추정된다.
메디포스트 관계자는 “뉴로스템은 기존에 개발중인 대부분의 치료제들과 달리 다양한 기전을 통한 복합적 치료라는 특징을 가지고 있어 알츠하이머병 치료의 새로운 가능성을 보여줄 것으로 기대한다”며 “임상 결과에 따라 다음 단계에 대한 논의를 이어갈 것”이라고 말했다.
뉴로스템 관련 연구는 보건복지부 보건의료연구개발사업 ‘줄기세포·재생의료 실용화 컨소시엄’ 과제의 지원을 받았다.




